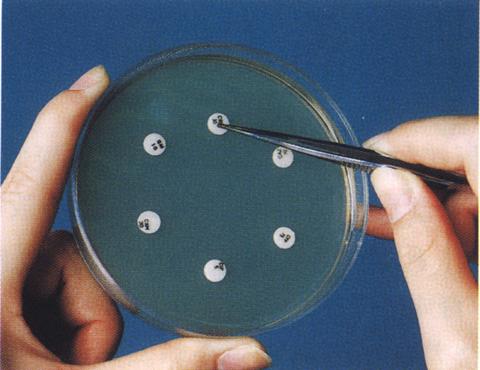
药敏试验

琼脂扩散试验

琼脂扩散试验的相关症状
图片尺寸450x337
琼脂扩散试验 - 知乎
图片尺寸465x353
抗体效价的监测检测
图片尺寸690x335
琼脂扩散试验 - 知乎
图片尺寸513x334
图片浏览
图片尺寸414x235
测量装置的制造及其应用技术
图片尺寸734x710
琼脂扩散试验的介绍
图片尺寸230x300
学实验 于红 病原生物学实验室常用仪器设备及试剂 单向琼脂扩散试验
图片尺寸800x800
一种海氏肠球菌间接血凝抗体检测试剂盒及其制备方法与流程
图片尺寸1000x868
药敏试验
图片尺寸480x370
israeli researchers develop method for 30-second b
图片尺寸974x650
1-2007抗菌检测 琼脂平皿扩散法
图片尺寸500x375
色素扩散实验
图片尺寸2667x2000
教材《医学免疫学》-胡圣尧,配套课件 (1)单向琼脂扩散试验
图片尺寸1080x810
新型抗菌肽菌丝霉素被认为有望替代抗生素的理想药物
图片尺寸634x639
1,双向琼脂扩散试验 原理:琼脂凝胶是一种半固体胶状物,里面 有无数
图片尺寸1080x810
iso206452004琼脂平板扩散法抗菌检测抗菌评价检测
图片尺寸500x375
琼脂扩散实验
图片尺寸920x690
自制字幕纸片扩散法检验抗生素效果
图片尺寸1280x720
p>抑菌圈法又叫扩散法,是利用待测药物在琼脂平板中扩散使其周围的
图片尺寸3320x2196